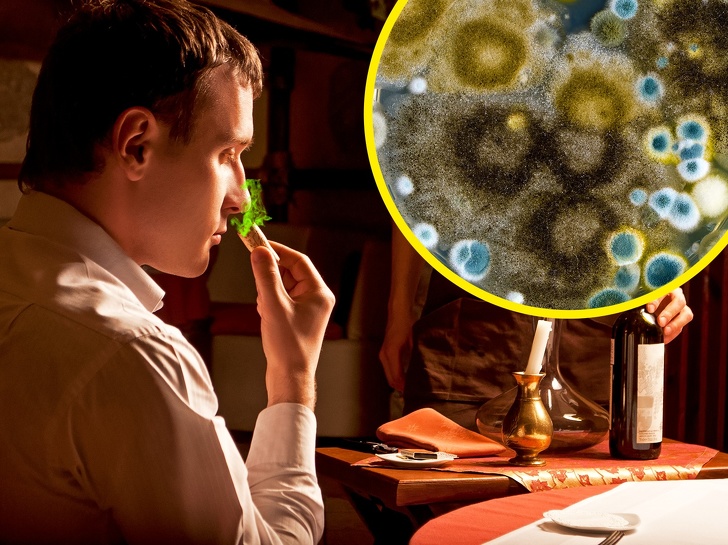

Дізнайтеся, навіщо офіціант дає нам пробувати вино в ресторані і як себе вести, щоб не здатися невігласом

Ви замовляєте пляшку вина, офіціант або сомельє приносить її, відкорковує і пропонує вам. Схоже на страшний сон, вірно? Адже у багатьох людей така ситуація викликає незручність: що робити далі? Нюхати? Зробити ковток і зі знанням справи причмокнуть? Чому б взагалі просто не відкрити пляшку і залишити вас у спокої? Якщо ви теж не впевнені у відповідях на ці питання, то швидше читайте нашу статтю.
Social.org.ua розібрався покроково, для чого нам пропонують спробувати вино з тільки що відкритої пляшки і що взагалі потрібно робити в такому випадку, щоб не схибити.
Крок № 1. Офіціант або сомельє приносить і показує вам пляшку
- Для чого?
Вам пропонують переконатися, що це саме те вино, яке ви замовляли. Адже офіціанти теж люди і могли схопити з полиці помилково не ту пляшку.
- Що потрібно робити?
Вдумливо прочитати етикетку, звернути увагу на рік врожаю.
Крок № 2. Працівник ресторану відкорковує вино і подає вам пробку
- Для чого?
Це робиться для того, щоб ви переконалися, що пробка в належному стані, немає неприємного запаху затхлості, цвілі, грибка. Пробка чиста, і вона не повинна легко кришитися.
Справа в тому, що близько 2 % вин заражені так званої «пробкової хворобою» — ситуація, коли виробляється речовина, відома як ТСА, під впливом взаємодії розчинів хлору для стерилізації пробок з коркової цвіллю. Це надає вину неприємний затхлий запах і неприємний смак.
- Що потрібно робити?
Розгляньте пробку. Деякі люди по недосвідченості вважають, що, понюхавши пробку, можна відчути нотки вина. Насправді намагатися вдихнути через неї аромат вина безглуздо. Ви можете понюхати пробку, якщо хочете, але лише для того, щоб переконатися: вино точно не заражене «пробкової хворобою».
Крок № 3. Офіціант наливає трохи вина в ваш келих і чекає
- Для чого?
Це саме той момент, коли ви повинні остаточно вирішити, чи приймаєте ви вино чи ні. Зрозуміло, для того, щоб відмовитися від вина і попросити заміну, у вас повинні бути вагомі підстави. Ви не можете попросити унести вино тільки тому, що воно виявилося не того смаку, який ви очікували. Однак якщо вино має неприємний запах або смак цвілі, затхлості, «мокрих рушників» — це привід до заміни напою.
- Що можна зробити?
- Спершу приділіть увагу кольором вина. Подивіться на нього на тлі контрастного білої скатертини. Корисно знати, що біле вино з віком стає темніше, а червоне — навпаки.
- Спробуйте вловити відтінок вина (теплий або холодний) та його окаемки. Дуже насичені теплі відтінки — це привід насторожитися. Відблиски окаемки темно-коричневого кольору в червоному вині або темно-помаранчева, морквяна окаемка в білому найчастіше говорять про те, що вино вже знаходиться на спаді.
- Переконайтеся, що немає осаду (крім допустимих випадків: в натуральних солодких винах, нефильтрованных і витриманих червоних винах. Також в сухих червоних винах і вінтажних портвейнах присутній так званий винний камінь).
- Візьміть келих за ніжку. Не трусіть його. Піднесіть келих до носа, але не занурюйте ніс у нього. Вдихніть первинний аромат вина. Розкачайте келих: «окресліть коло вином, і тоді ви почуєте вторинний і третинний (якщо він є) аромати.
- Спробуйте вино, переконайтеся, що воно не має поганого смаку. Пам'ятайте, що вино — непостійний продукт, тому його більш кислий, ніж ви очікували, смак — це не привід від нього відмовитися.
- Кивните сомельє, і він наповнить келихи інших гостей за столом.
Ось і все, тепер ви не розгубитеся, коли в ресторані офіціант або сомельє принесе вам пляшку вина. Ці ритуали достатні прості і спрямовані в основному на те, щоб ви самостійно переконалися: вино саме те, що ви замовили, і воно в повному порядку.
Фото на превью depositphotos, depositphotos